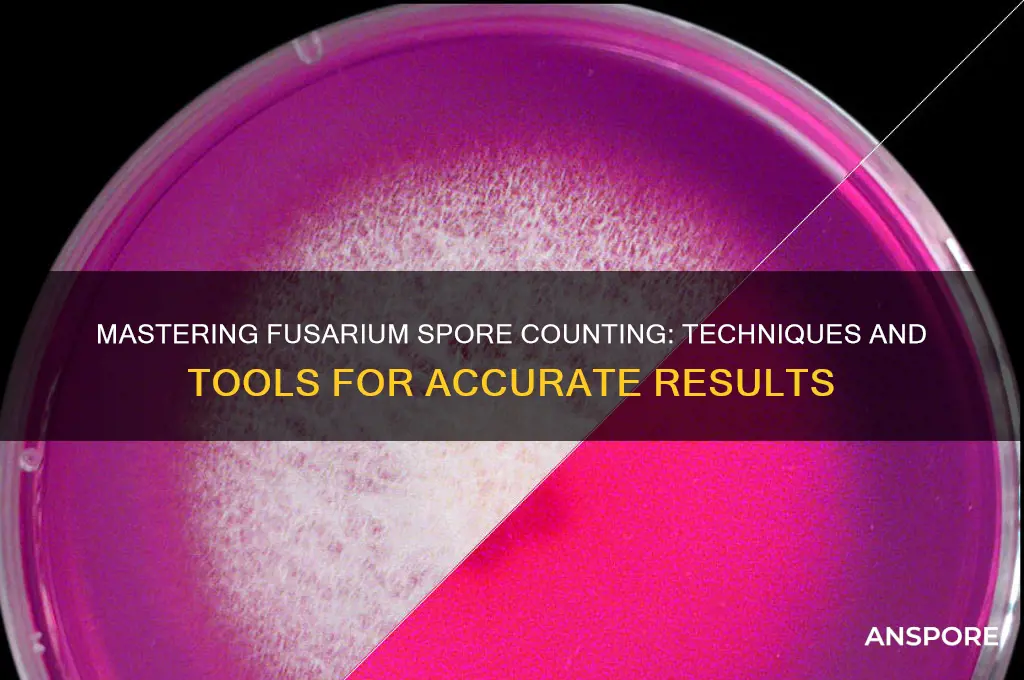
how to count fusarium spor

Counting Fusarium spores is a critical process in agricultural and environmental monitoring, as these fungi can cause significant crop diseases and impact food safety. The method typically involves collecting spore samples using air samplers or spore traps, followed by microscopic examination or molecular techniques like quantitative PCR. Samples are often suspended in a liquid medium, and a hemocytometer or automated counters are used to quantify spore concentrations accurately. Proper identification and enumeration of Fusarium spores are essential for assessing disease risk, implementing control measures, and ensuring the health of crops and ecosystems.
| Characteristics | Values |
|---|---|
| Method | Microscopy (most common), Quantitative PCR (qPCR), Spore Trapping, Plate Counting |
| Sample Preparation | Soil: Dilution and filtration, Plant Tissue: Surface sterilization, homogenization, Air: Spore traps with adhesive slides or filters |
| Staining (Microscopy) | Calcofluor White, Trypan Blue, Lactophenol Cotton Blue |
| Microscopy Type | Fluorescence microscopy (for stained spores), Brightfield microscopy |
| Counting Chamber | Hemocytometer, Counting slides with grids |
| Data Analysis | Manual counting, Image analysis software (e.g., ImageJ) |
| qPCR Advantages | High sensitivity, Specificity to Fusarium species |
| Spore Trapping Advantages | Direct air sampling, Useful for monitoring airborne spores |
| Plate Counting Advantages | Quantitative, Can identify viable spores |
| Limitations | Microscopy: Time-consuming, requires expertise; qPCR: Requires specific primers, expensive; Spore Trapping: May underestimate total spores; Plate Counting: Underestimates non-viable spores |
| Applications | Disease monitoring, Research on Fusarium biology, Seed health testing, Environmental monitoring |
Explore related products
What You'll Learn
- Sample Preparation Techniques: Methods for collecting and preparing plant/soil samples for accurate spore counting
- Microscopic Counting Methods: Using hemocytometers or slides to manually count Fusarium spores under a microscope
- Flow Cytometry Applications: Automated spore counting using flow cytometry for high-throughput analysis
- Molecular Detection Tools: PCR and qPCR techniques to quantify Fusarium spores via DNA amplification
- Spore Trapping Devices: Utilizing air samplers or sticky traps to capture and count airborne Fusarium spores

Sample Preparation Techniques: Methods for collecting and preparing plant/soil samples for accurate spore counting
Accurate spore counting begins with meticulous sample preparation, a critical step often overlooked in Fusarium studies. Improper collection or handling can introduce biases, leading to underestimates or overestimates of spore concentrations. For instance, soil samples collected during peak moisture conditions may yield higher spore counts due to increased fungal activity, but this doesn’t necessarily reflect baseline levels. Similarly, plant tissue samples must be processed promptly to prevent spore degradation or overgrowth of contaminating microorganisms. Understanding these nuances ensures that the data collected is both reliable and reproducible.
Collection Techniques: Precision in the Field
For soil samples, a systematic approach is essential. Use a sterile soil corer to collect subsamples from multiple locations within a plot, ensuring representativeness. Composite samples, created by combining 10–15 subsamples, provide a more accurate picture of spore distribution. For plant material, select symptomatic tissues (e.g., lesions or wilted leaves) as they are more likely to harbor spores. Sterilize cutting tools with 70% ethanol between samples to prevent cross-contamination. Both soil and plant samples should be stored in sealed, sterile bags and kept at 4°C for transport to the lab, minimizing exposure to environmental conditions that could alter spore viability.
Preparation Methods: From Field to Microscope
Once in the lab, soil samples are typically processed using a wet sieving technique. Mix 10 grams of soil with 100 mL of sterile distilled water, agitate for 2 minutes, and filter through a 40-mesh sieve to remove debris. The filtrate is then centrifuged at 3000 rpm for 10 minutes to concentrate spores. For plant tissues, surface sterilization is crucial. Rinse samples in 70% ethanol for 1 minute, followed by 0.5% sodium hypochlorite for 3 minutes, and finally rinse with sterile water to remove residual chemicals. Blotting tissues dry before spore extraction prevents dilution of the spore suspension. These steps ensure that the target spores are isolated from extraneous material, enhancing counting accuracy.
Extraction and Concentration: Maximizing Yield
Spore extraction from plant tissues often involves a blender method. Place 5 grams of tissue in 50 mL of sterile water, blend for 30 seconds, and filter through cheesecloth to remove large particles. The filtrate can be further concentrated using a centrifuge or by allowing spores to settle overnight. For soil extracts, a sugar gradient centrifugation (e.g., 50% sucrose solution) can separate spores from lighter soil particles. These techniques not only increase spore recovery but also reduce background interference, making microscopic enumeration more straightforward.
Quality Control: Ensuring Consistency
Even with careful preparation, contamination and variability can skew results. Incorporate negative controls (sterile water or soil) in every batch to detect lab contaminants. Replicate samples (n≥3) are essential for statistical robustness. For long-term storage, preserve samples in 15% glycerol at -20°C, which maintains spore viability without inducing germination. Regularly calibrate lab equipment (e.g., centrifuges, balances) to ensure consistency across experiments. By adhering to these protocols, researchers can minimize errors and produce data that accurately reflects Fusarium spore populations in their samples.
Do Free Spores Stain Green? Unveiling the Truth Behind the Myth
You may want to see also

Microscopic Counting Methods: Using hemocytometers or slides to manually count Fusarium spores under a microscope
Fusarium spores, being microscopic in size, require precise techniques for accurate quantification. One of the most traditional and reliable methods is the use of hemocytometers or slides for manual counting under a microscope. This technique, while labor-intensive, offers direct visualization and control over the counting process, making it a gold standard in many laboratories.
Steps for Microscopic Counting:
- Sample Preparation: Dilute the Fusarium spore suspension in a sterile solution, such as distilled water or a buffer, to ensure an even distribution and prevent overcrowding on the counting grid. A typical dilution range is 1:10 to 1:100, depending on the initial spore concentration.
- Loading the Hemocytometer: Place a clean hemocytometer on a flat surface. Using a pipette, carefully add 10 μL of the diluted spore suspension to the chamber. Allow the liquid to fill the grid by capillary action, avoiding air bubbles.
- Microscopic Examination: Position the hemocytometer under a light microscope at 400x magnification. Focus on the grid squares, typically 1 mm² in area, divided into 16 smaller squares (0.0625 mm² each). Count the spores in a consistent number of squares, usually 4–5, to ensure accuracy.
- Calculation: Multiply the average number of spores per square by the dilution factor and the volume factor (10,000 for a 1 mm² grid) to determine the concentration in spores per milliliter. For example, if you count 10 spores in 5 squares at a 1:10 dilution, the concentration is \( \frac{10 \times 5 \times 10,000}{10} = 50,000 \) spores/mL.
Cautions and Practical Tips:
- Ensure the hemocytometer is clean and free of debris to avoid counting errors.
- Use a coverslip to create an even chamber depth and prevent evaporation during counting.
- Stain the spores with a dye like lactophenol cotton blue to enhance visibility and confirm viability, though this is optional for simple counts.
- Maintain consistent lighting and focus to avoid missing spores or double-counting.
Comparative Advantage:
While automated methods like flow cytometry offer speed, microscopic counting provides unparalleled control and the ability to visually verify spore morphology. This method is particularly useful in research settings where accuracy trumps throughput, or when resources for advanced equipment are limited.
Manual counting of Fusarium spores using hemocytometers or slides remains a cornerstone technique for its precision and reliability. With careful preparation and attention to detail, this method yields accurate spore counts essential for plant pathology, mycology, and agricultural research.
Can Carbon Filters Effectively Remove Mold Spores from Indoor Air?
You may want to see also

Flow Cytometry Applications: Automated spore counting using flow cytometry for high-throughput analysis
Flow cytometry has emerged as a powerful tool for automated spore counting, offering unparalleled precision and efficiency in high-throughput analysis. Unlike traditional methods such as hemocytometry or microscopy, which are labor-intensive and prone to human error, flow cytometry enables rapid quantification of *Fusarium* spores by analyzing individual particles in a liquid suspension. This technique leverages laser-based detection to measure parameters like size, granularity, and fluorescence, allowing for accurate differentiation of spores from debris or other contaminants. For researchers and diagnosticians, this means faster, more reliable data collection, particularly when dealing with large sample volumes or time-sensitive applications.
To implement flow cytometry for *Fusarium* spore counting, begin by preparing a homogeneous spore suspension in a sterile buffer, such as phosphate-buffered saline (PBS), to ensure optimal flow through the cytometer. Concentrations should ideally fall within the range of 10^4 to 10^6 spores/mL, as this minimizes clogging while providing sufficient events for analysis. Fluorescent staining with viability dyes like SYBR Green or propidium iodide can enhance detection by differentiating live spores from dead or damaged ones. Calibration is critical; use standardized beads (e.g., 2–6 μm polystyrene beads) to establish size gates and ensure accurate spore enumeration. Once optimized, the system can process hundreds of samples per day, making it ideal for agricultural monitoring, food safety testing, or epidemiological studies.
One of the standout advantages of flow cytometry is its ability to combine spore counting with phenotypic analysis. For instance, by incorporating fungal-specific antibodies or fluorescent markers, researchers can simultaneously quantify *Fusarium* spores and assess traits like toxin production or resistance profiles. This dual functionality not only streamlines workflows but also provides deeper insights into spore behavior and population dynamics. However, users must be mindful of potential pitfalls, such as spore aggregation or instrument contamination, which can skew results. Regular cleaning of the cytometer and inclusion of internal controls are essential to maintain data integrity.
When comparing flow cytometry to conventional methods, the benefits are clear. Microscopy, while visually intuitive, is time-consuming and subjective, often requiring trained personnel to distinguish spores from background noise. Hemocytometry, though simpler, lacks the sensitivity to detect smaller spores or differentiate viability. Flow cytometry bridges these gaps, offering both speed and specificity. For example, a study comparing flow cytometry to plate counting for *Fusarium graminearum* spores found that the former reduced analysis time by 70% while maintaining 95% accuracy. Such efficiency gains are particularly valuable in industries like grain production, where rapid detection of mycotoxin-producing spores can prevent crop losses.
In conclusion, automated spore counting using flow cytometry represents a transformative approach for *Fusarium* analysis, blending high-throughput capability with advanced phenotypic characterization. By adhering to best practices in sample preparation, calibration, and quality control, users can harness this technology to address complex challenges in agriculture, food safety, and beyond. As flow cytometry continues to evolve, its role in spore quantification is likely to expand, further solidifying its position as a cornerstone of modern fungal research.
Spore Piracy: Uncovering the Shocking Number of Illegal Downloads
You may want to see also
Explore related products

Molecular Detection Tools: PCR and qPCR techniques to quantify Fusarium spores via DNA amplification
Fusarium spores are microscopic, making traditional counting methods labor-intensive and prone to error. Molecular detection tools like PCR (Polymerase Chain Reaction) and qPCR (quantitative PCR) offer a precise alternative by amplifying specific DNA sequences unique to Fusarium, enabling accurate quantification even in complex samples. These techniques bypass the limitations of microscopy, providing a rapid and sensitive approach to spore detection.
Example: In a study assessing Fusarium contamination in wheat grains, qPCR detected spore levels as low as 10 spores/gram, compared to 100 spores/gram for traditional plating methods.
Steps for PCR-Based Fusarium Spore Quantification:
- DNA Extraction: Isolate fungal DNA from the sample (soil, plant tissue, or food) using commercial kits or phenol-chloroform extraction. Aim for high-quality DNA free from inhibitors like humic acids.
- Primer Design: Select primers targeting a conserved region of the Fusarium genome, such as the translation elongation factor 1-alpha (TEF1-α) gene. Primer length should be 18–25 nucleotides, with a melting temperature (Tm) of 58–62°C.
- PCR Amplification: Perform PCR using a thermocycler with 30–40 cycles of denaturation (95°C), annealing (55–60°C), and extension (72°C). Include a positive control (known Fusarium DNA) and a negative control (sterile water).
- Quantification (qPCR): For absolute quantification, create a standard curve using serial dilutions of a plasmid containing the target sequence. Cycle threshold (Ct) values from unknown samples are compared to the curve to estimate spore concentration.
Cautions and Considerations:
PCR and qPCR are powerful but require careful optimization. Inhibitors in soil or plant matrices can reduce amplification efficiency, leading to false negatives. To mitigate this, test DNA extracts for inhibition by spiking with exogenous DNA (e.g., phage lambda DNA) and comparing Ct values. Additionally, primer specificity is critical; non-specific binding can inflate results. BLAST searches and gradient PCR can verify primer binding to the intended target.
Practical Tips for Success:
- Use certified reference materials (CRMs) for calibration to ensure accurate quantification.
- Include an internal amplification control (IAC) to detect inhibition in real-time.
- Store DNA extracts at -20°C to prevent degradation, and aliquot to avoid freeze-thaw cycles.
- For qPCR, ensure the R² value of the standard curve is ≥0.99 and the efficiency is 90–110% for reliable quantification.
PCR and qPCR techniques revolutionize Fusarium spore quantification by offering sensitivity, specificity, and speed. While traditional methods remain valuable, molecular tools are indispensable for applications requiring high precision, such as food safety monitoring or disease epidemiology. By following best practices and addressing potential pitfalls, researchers can harness these techniques to accurately measure Fusarium spore loads in diverse environments.
Are Spore Servers Down Permanently? Exploring the Game's Online Status
You may want to see also

Spore Trapping Devices: Utilizing air samplers or sticky traps to capture and count airborne Fusarium spores
Airborne Fusarium spores pose a significant threat to agriculture, particularly in cereal crops, where they can cause Fusarium head blight (FHB), a devastating disease leading to yield losses and mycotoxin contamination. To mitigate this risk, early detection is crucial, and spore trapping devices have emerged as a vital tool in monitoring Fusarium spore concentrations. These devices, which include air samplers and sticky traps, provide a quantitative measure of airborne spores, enabling farmers and researchers to make informed decisions about disease management strategies.
Air Samplers: A Proactive Approach
Air samplers operate by drawing a known volume of air through a collection medium, typically a filter or agar plate, which captures airborne spores. The most common type, the Burkard spore trap, uses a rotating arm to impact spores onto a sticky surface, allowing for subsequent microscopic identification and counting. To ensure accurate results, it is essential to calibrate the sampler to a specific flow rate, typically 10 liters per minute, and to collect samples over a standardized period, such as 7 days. This method is particularly useful for large-scale monitoring, as it provides a representative sample of the aerial spore population. For instance, in a study on wheat fields, air samplers detected a significant increase in Fusarium spores 7-10 days before the onset of FHB symptoms, highlighting the value of this technique in early disease detection.
Sticky Traps: A Simple yet Effective Solution
In contrast to air samplers, sticky traps offer a more straightforward and cost-effective approach to spore trapping. These devices consist of a flat surface coated with a sticky adhesive, which captures spores as they settle from the air. To maximize efficiency, place traps at a height of 1-1.5 meters above the crop canopy, ensuring they are level and securely fastened to avoid detachment. Leave the traps in place for 7-14 days, depending on the desired sampling period, and then carefully remove them for laboratory analysis. A key advantage of sticky traps is their ease of use and low maintenance requirements, making them ideal for small-scale or resource-limited settings. However, it is crucial to consider the potential for contamination and to handle traps with care to avoid introducing foreign particles.
Best Practices and Considerations
When utilizing spore trapping devices, several factors must be considered to ensure accurate and reliable results. Firstly, the placement of traps is critical, as it can significantly influence the number and type of spores captured. Ideally, traps should be located in representative areas of the field, away from field edges and other potential sources of contamination. Additionally, the sampling frequency should be tailored to the specific crop and disease dynamics, with more frequent sampling recommended during periods of high disease pressure. It is also essential to maintain a consistent sampling protocol, including the use of standardized collection media and laboratory analysis techniques. For example, when counting spores, use a hemocytometer or a gridded microscope slide to ensure accurate quantification, and consider using a spore viability stain, such as fluorescein diacetate, to distinguish between viable and non-viable spores.
Integrating Spore Trapping Data into Disease Management
The data generated from spore trapping devices can be a powerful tool in informing disease management decisions. By establishing threshold values for Fusarium spore concentrations, farmers can implement targeted control measures, such as fungicide applications or crop rotation, to minimize disease risk. For example, a study in barley fields found that a spore concentration threshold of 1000 spores/m³ was associated with a significant increase in FHB incidence, providing a valuable reference point for disease management. Furthermore, the integration of spore trapping data with other disease forecasting tools, such as weather models and crop growth stage information, can enhance the accuracy and effectiveness of disease prediction systems. As the threat of Fusarium diseases continues to grow, the strategic use of spore trapping devices will play an increasingly important role in safeguarding crop health and productivity.
Mastering Plague Inc.: Strategies to Outsmart and Defeat Spores Effectively
You may want to see also
Frequently asked questions
The most common method is the hemocytometer technique. Dilute the spore suspension, load it into a hemocytometer, and count the spores under a light microscope at 400x magnification. Alternatively, flow cytometry or quantitative PCR can be used for more precise measurements.
Harvest spores from a culture by gently scraping the surface with a sterile loop or washing with sterile water. Filter the suspension through a fine mesh to remove debris, then dilute it with sterile water or a buffer solution to achieve a countable concentration.
Aim for a concentration of 10^4 to 10^6 spores per milliliter for accurate counting using a hemocytometer. If the concentration is too high, dilute the sample further; if too low, concentrate it by centrifugation or evaporation.











